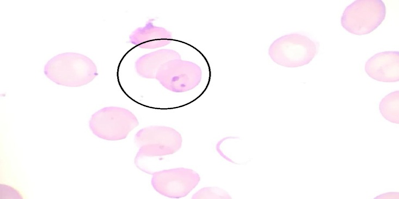

Dr. Aliye Tanrıcı
26 yaşında 10 haftalık gebe hasta, 38 Cºateş, üşüme titreme şikayetleri ile başvurdu. Başvurusundan 20 gün öncesinde Afrika’ya seyahat öyküsü olan ve 5 gündür devam eden semptomları olan hastanın periferik yayması Şekil’de görülmektedir. Aşağıdakilerden hangisi bu hastada en uygun tedavi seçeneğidir?













